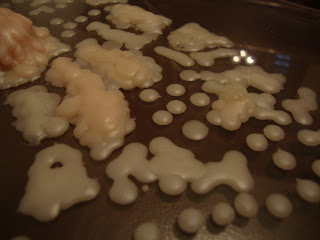

Juan Vandemberg
martes, 29 de noviembre de 2011
martes, 22 de noviembre de 2011
martes, 8 de noviembre de 2011
problema solucion
el ultimo boceto consiste en mordazas para sostener la tanza de la bordeadora para facilitar su extraccion.
miércoles, 26 de octubre de 2011
posible tercer proyecto (problema/solucion)
por lo pronto andamos con dos...uno es la solución al clásico problema de la tapa del inodoro utilizando un resorte circular usado para puertas que cierran solas y el segundo corresponde a una almohada para adherir al cinturón de seguridad con tensores para mantenerlo trabado.
domingo, 9 de octubre de 2011
Vosfi
Continuando con el segundo proyecto... Ahora represento el consumo eléctrico anual por provincia con la misma metodología pero para el año 1970.!!!¡¡
En las fotos siguientes se muestra la comparación entre las 2 representaciones. 1970 (izq) y 2007 (der)
La tabla mustra el consumo de electricidad en MWh.
Una gota corresponde a 100000 MWh.
En las fotos siguientes se muestra la comparación entre las 2 representaciones. 1970 (izq) y 2007 (der)
La tabla mustra el consumo de electricidad en MWh.
Una gota corresponde a 100000 MWh.
viernes, 7 de octubre de 2011
segundo proyecto
El segundo proyecto de Infoestética consiste en representar el consumo eléctrico anual de cada provincia con una cantidad proporcional de gotas de cera de una vela.
Facturacion anual por provincia en MWh
Fuente: Secretaria de Energía de la Nación
Cada Gota corresponde a 100000 MWh
miércoles, 28 de septiembre de 2011
posibles segundos proyectos
La primera opcion es reconstruir el mapa del territorio argentino con los paises de origen de los extranjeros viviendo en Argentina.
Otra es representar el consumo energetico de las provincias con gotas de vela derretidaRepresentar la densidad de poblacion de cada provincia con elementos de distintas densidades
Suscribirse a:
Entradas (Atom)